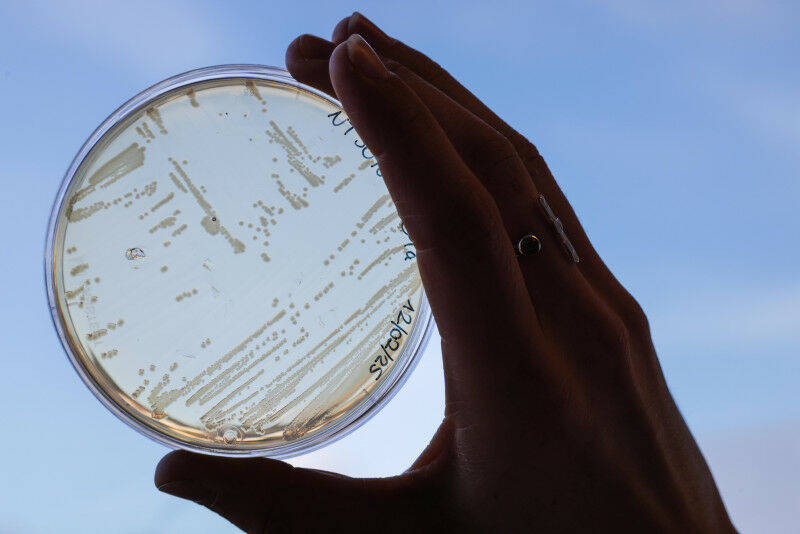

Unser Verdauungssystem beherbergt etwa 1,5 kg Bakterien. Die Darmmikrobiota wurde von der Medizin lange Zeit ignoriert, hat aber in den letzten Jahren wieder an Interesse gewonnen. Ihr Einfluss geht weit über die Verdauung hinaus: Sie interagiert mit unserer Immunität, unserem Stoffwechsel und sogar unserer geistigen Gesundheit. Dennoch ist dieses riesige Ökosystem für die Wissenschaft noch immer ein Rätsel.
Mit fast 1.000 verschiedenen Stämmen ist die Darmmikrobiota die dichteste und vielfältigste im menschlichen Körper. "Diese Bakterien erfüllen spezifische Funktionen, die je nach ihrem Stoffwechsel variieren", erklärt Camille Goemans, Professorin am Laboratoire d’interaction médicament-microbiote an der EPFL. Sie sind an der Verdauung von Nahrungsfasern, der Produktion von Vitaminen, dem Training des Immunsystems, dem Schutz des Darms, der Regulierung des Gewichts und des Stoffwechsels, aber auch an der Aufrechterhaltung einer guten psychischen Gesundheit beteiligt.
Inzwischen treten immer mehr Krankheiten auf, von denen man bisher nicht wusste, dass sie mit der Mikrobiota in Verbindung stehen. Dazu gehören Allergien, Fettleibigkeit, Autismus und Autoimmunerkrankungen. "Diese Erkrankungen waren vor einem Jahrhundert noch selten. Heute explodiert die Prävalenz von Allergien, und dieser Anstieg scheint direkt mit dem Zustand unserer Mikrobiota zusammenzuhängen", betont Camille Goemans. Die Industrialisierung, Bewegungsmangel und eine verarbeitete Ernährung hätten unsere Mikrobiota verändert, so die Wissenschaftlerin. Inwiefern ist die Mikrobiota ein Schlüsselfaktor für unsere Gesundheit?
Eine Mikrobiota, die von Geburt an aufgebaut wird
Der Einfluss der Mikrobiota beginnt mit der Geburt, einem entscheidenden Moment in ihrer Entstehung. Ein Baby wird ohne Mikrobiota geboren. Im Mutterleib befindet es sich in einem völlig sterilen Feld. Erst während der Geburt und beim Durchtritt durch den Geburtskanal nimmt es seine ersten Bakterien auf, nämlich die der Vaginalflora seiner Mutter. Seine Mikrobiota wird beim Stillen durch Hautbakterien ergänzt. "Babys, die per Kaiserschnitt geboren werden oder mit der Flasche ernährt werden, haben eine weniger vielfältige Mikrobiota, was sie anfälliger für bestimmte Krankheiten macht", erklärt die Forscherin von der Fakultät für Biowissenschaften. Einige Geburtskliniken versuchen, dem entgegenzuwirken, indem sie diese Babys gleich nach der Geburt in ein Tuch einwickeln, das mit der Vaginalflora der Mutter getränkt ist.Die Mikrobiota stabilisiert sich ab dem Alter von drei Jahren und wird dann das ganze Leben lang durch Ernährung, Stress, körperliche Betätigung, Krankheiten und die Einnahme von Antibiotika beeinflusst, die die bakterielle Vielfalt verringern. "Je vielfältiger sie ist, desto besser trägt sie zu unserer guten Gesundheit bei", stellt Camille Goemans fest.
Je vielfältiger die Mikrobiota ist, desto besser trägt sie zu unserer guten Gesundheit bei
Camille Goemans
Eine Beeinträchtigung dieser Darmflora kann dann Krankheiten wie Allergien, Autoimmunerkrankungen oder Verdauungsstörungen wie Morbus Crohn und das Reizdarmsyndrom begünstigen. "Bei letzteren muss auch der genetische Faktor berücksichtigt werden. Die Mikrobiota hält eine Schutzbarriere im Darm aufrecht. Wenn sie versagt, ist die Barriere weniger wirksam und macht Platz für Entzündungen, die dann den Zustand der Krankheit verschlimmern. Es handelt sich um einen Teufelskreis, der eine Behandlung erschwert", stellt die Wissenschaftlerin fest.
Medizinische Lösungen
Da die Mikrobiota eine wichtige Rolle für eine gute körperliche und geistige Gesundheit spielt, untersucht die Forschung zwei Wege, um eine gesunde Mikrobiota wiederherzustellen: Probiotika und Stuhltransplantation. "Probiotika sind lebende Bakterien, die in fermentierten Lebensmitteln oder in Form von Nahrungsergänzungsmitteln erhältlich sind", erklärt Camille Goemans. Die Wirksamkeit ist nicht wissenschaftlich belegt und variiert je nach Person und Stamm.Zur Pflege der Mikrobiota empfiehlt Camille Goemans eine Ernährung, die reich an fermentierten Lebensmitteln wie Joghurt, Sauerkraut, Kimchi, Kombucha oder Kefir ist, aber auch reich an Ballaststoffen (die in Gemüse, Obst und Vollkorngetreide vorkommen), die die "guten" Bakterien der Mikrobiota ernähren. Im Gegensatz dazu fördern verarbeitete und zuckerreiche Lebensmittel die Vermehrung schädlicher Bakterien auf Kosten der anderen.
Die wissenschaftliche Gemeinschaft stellt sich die Frage, wie eine gesunde Mikrobiota zu definieren ist. Wir haben noch nicht alle Antworten gefunden.
Camille Goemans
Bei der Fäkaltransplantation wird die Mikrobiota eines gesunden Spenders entnommen und einem Patienten wieder zugeführt. Diese Technik wird derzeit nur gegen die Infektion mit Clostridioides difficile eingesetzt, einer schweren, gegen Antibiotika resistenten Darmerkrankung. Sie führt zu schweren Durchfällen, Übelkeit und Krämpfen. Unbehandelt kann diese Krankheit tödlich verlaufen. "Mit der Stuhltransplantation liegt die Erfolgsquote bei fast 90%", sagt die Assistenzprofessorin.
Es bleibt eine wichtige Frage: Wie kann man eine gesunde Mikrobiota definieren und die Qualität des Spenders sicherstellen? "Wir wissen es nicht. Die wissenschaftliche Gemeinschaft stellt sich die Frage nach der Definition einer gesunden Mikrobiota. Wir haben noch nicht alle Antworten gefunden. Außerdem ist die Forschung über die Mikrobiota noch relativ jung. Wir haben noch keine langfristigen Erfahrungen damit, wie sich beispielsweise eine implantierte Mikrobiota entwickelt", sagt Camille Goemans.
Antibiotika, der Feind der Mikrobiota
Die Wissenschaftlerin führt in ihrem Labor Forschungen durch, um zu verstehen, wie Antibiotika und andere Medikamente die verschiedenen Bakterien der Darmmikrobiota beeinflussen und wie diese an der Entwicklung von Antibiotikaresistenzen beteiligt sind. "Antibiotika sind Moleküle, die Bakterien abtöten, um eine Infektion zu beenden. Die heutigen Antibiotika unterscheiden nicht zwischen nützlichen und pathogenen Bakterien. Wenn eine Person ein Antibiotikum oral einnimmt, wird ein Teil der Darmmikrobiota zerstört", warnt Camille Goemans. Während sich bei manchen Menschen die Darmflora nach der Behandlung auf natürliche Weise erholt, kommt es bei anderen zu einem dauerhaften Ungleichgewicht.Die Wissenschaft versucht, gezielte Behandlungsmethoden zu entwickeln, die Infektionen beseitigen können, ohne die gesamte Mikrobiota zu zerstören. Sie bemüht sich auch darum, die genaue Rolle der einzelnen Darmbakterien besser zu verstehen. "Bevor wir etwas für die Gesundheit tun können, müssen wir erst einmal diese Wechselwirkungen entschlüsseln", betont Camille Goemans.
Für die Forscherin ist es entscheidend, den menschlichen Körper als ein Ökosystem zu betrachten. Eine ausgewogene Ernährung und ein gesunder Lebensstil sind die besten Verbündeten für eine gesunde Mikrobiota und damit für eine gute körperliche und geistige Gesundheit. Um zu verstehen, wie wichtig die Mikrobiota ist, führen Forscher Experimente mit axenischen Mäusen durch, d. h. mit Mäusen, die keine Darmflora haben. Das Ergebnis: In einer normalen Umgebung überleben sie nur drei Tage.




